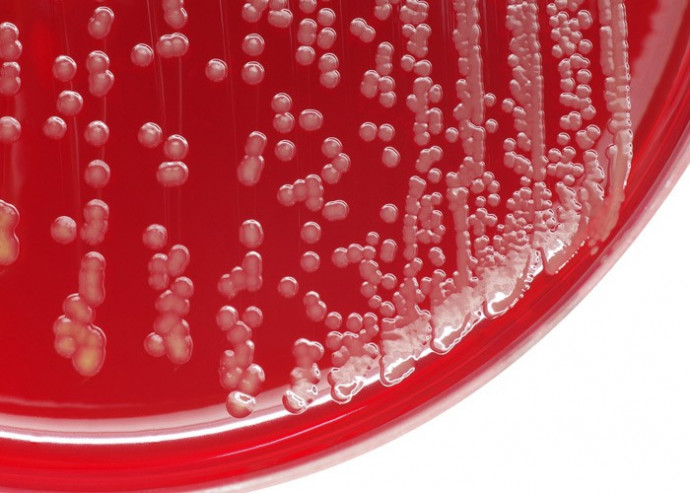
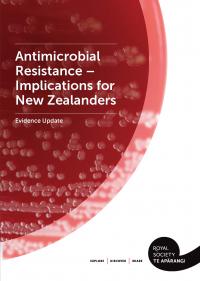
Antimicrobial resistance factsheet May 2017 cover

Antimicrobial resistance
2017: Many microbes that commonly cause infectious disease in humans and animals are becoming resistant to the antimicrobial medicines used to treat these diseases.
This evidence update, factsheet, supporting videos and media release summarise the latest about antimicrobial resistance in New Zealand.